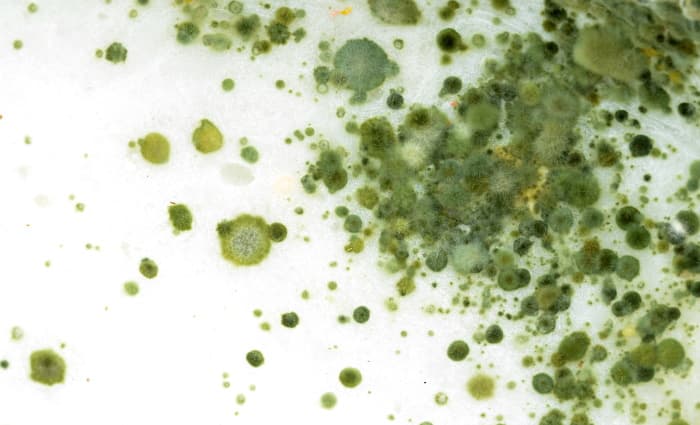
Mold

When you discover a Mold issue in your home, there are a lot of things that go through your mind. How serious is it? How do you get rid of it? How likely is it to come back?
And these are all great questions that we’re going to try to answer!
How serious is it?
Often the severity of a Mold issue can be difficult to judge. This is because, while you may see some on your wall or base molding, it’s likely far worse inside wall or ceiling cavities where you can’t see!
Determining the severity of a mold issue requires expertise and an understanding of both moisture and mold growth. This is why, during our inspection, we spend so much time attempting to trace where the moisture likely came from and what building materials are likely affected. Only after understanding what is occurring are we able to put together a plan to properly address the mold issue.
How do you get rid of it?
Mold Remediation is a labor intensive process that includes detailed cleaning, access to contaminated cavities and other inaccessible areas, and the filtering of mold spores out of the air. The goal is to remove as much of the mold growth and mold spores as possible through an extremely diligent process.
Some less reputable contractors may attempt to sell you on “too good to be true” processes such as spray treatments that will “kill” or “eliminate” the mold or “tearout-free” projects that claim to be able to remove mold without accessing the areas that it’s growing in. As wonderful and convenient as these projects sound, these contractors are merely taking advantage of the desire many homeowners have to find a quick or easy solution.
How likely is it to come back?
Mold spores exist everywhere and need only the right conditions to begin to propagate and spread. This means that, should the moisture issue not be resolved, or future moisture issues develop, mold growth will be able to return. This is why a qualified mold remediation firm will attempt to determine the underlying cause of the moisture issue and make recommendations to either rectify or manage it.
In addition, if the mold remediation services were not completed properly, such as in cases where a spray treatment is applied, mold will be able to return quickly. In the circumstances where mold remediation is performed improperly by unqualified contractors, you may see mold return in as little as a few days! This is why it is so important to hire remediation firms that specialize in mold remediation and who have the background and expertise to do the job right.
For this reason, cutting corners or hiring unqualified contractors can not only be a waste of money, it can dramatically worsen the mold contamination in your home. This will require that the property be remediated a second time by a remediation firm that is able to address the mold issue properly. For this reason, we strongly recommend that you have mold issues address properly the first time.
We hope that answers some of your questions about Mold! If you have any questions that we did not address here, please don’t hesitate to contact your local Disaster Blaster! We’re happy to help!
Interested in older news stories? Please see our News Archive.